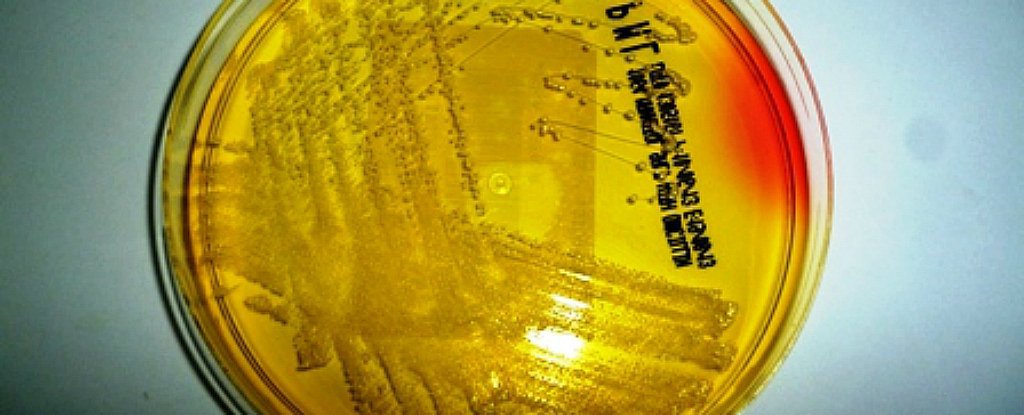

Các nhà khoa học vừa tìm thấy một hợp chất có thể tiêu diệt 98% vi khuẩn kháng thuốc
Càng ngày càng có nhiều loài vi khuẩn trở nên có sức đề kháng với thuốc kháng sinh, các nhà khoa học đã và đang tìm kiếm những cách thức mới để có thể chống lại sự kháng thuốc đó, đặc biệt là nhiễm trùng. Và nghiên cứu ban đầu cho thấy các miếng bọt biển Nam Cực có thể cho một lựa chọn tốt.
Staphylococcus aureus - hoặc tụ cầu - bệnh nhiễm trùng khá phổ biến, đặc biệt là ở bệnh viện và trong những trường hợp bình thường bệnh này không đặc biệt khó điều trị. Nhưng MRSA là một chủng biến dạng có khả năng phát triển sức đề kháng với hầu hết các loại thuốc kháng sinh chúng ta đã có sẵn, có nghĩa là nó có thể lây lan nhanh chóng từ một vết thương nhiễm trùng bề ngoài, chẳng hạn như nhiễm trùng da, rồi xâm lấn đến có thể đe dọa tính mạng.
Theo Trung tâm Kiểm soát dịch bệnh (CDC), ở Mỹ mỗi năm chuẩn đoán có khoảng 80.000 ca bệnh nhiễm trùng MRSA và 11.000 người chết vì biến chứng MRSA. Hiện tại chúng ta thực sự không có nhiều lựa chọn để chống lại chúng.
Đó là lý do tại sao sự phát hiện ra hợp chất mới này, còn được gọi là “darwinolide” rất thú vị. Các nhà nghiên cứu tìm thấy hợp chất bên trong một miếng bọt biển Nam Cực, Dendrilla membranosa và các xét nghiệm ban đầu đã cho thấy rằng nó có thể giết 98,4 phần trăm các tế bào MRSA.
"Đó là một hợp chất phòng thủ chống lại các vi khuẩn với một số đặc tính rất thú vị", James McClintock- một trong những nhà nghiên cứu từ Đại học Alabama ở Birmingham cho biết.
Đây không phải là lần đầu tiên mà các hợp chất y học thú vị đã được tìm thấy trong các sinh vật biển ở Nam Cực - McClintock và nhóm của ông đã xác định được một hợp chất trong miếng bọt biển có thể chống lại chủng H1N1 của virus cúm và một loại có tác dụng chống lại bệnh ung thư da melanoma.
Điều hấp dẫn các nhà sinh học là ở một số cơ chế phòng thủ mạnh, chẳng hạn như các hợp chất độc hại trong những sinh vật tồn tại được ở nơi mà cực kỳ khó khăn để sống.
"Bọt biển không được bảo vệ bởi vỏ và chúng không thể di chuyển xung quanh", McClintock nói. Ông cho biết thêm rằng điều này làm cho bọt biển không cần bất kỳ sự bảo vệ nào để chống lại các vi khuẩn độc hại trong môi trường sống dưới nước. Khi mà có sự rò rỉ, chúng sẽ luôn luôn tự đấu tranh để chống lại.
Bọt biển là giải pháp để sản xuất một loạt các "hợp chất khó chịu" mà có thể tiêu diệt vi khuẩn khi tiếp xúc với chúng với hy vọng giữ được sự tự miễn nhiễm.
Và nhóm của McClintock đã có thể tách những hợp chất darwinolide ra và đã cho biết nó có tiềm năng rất lớn, ít nhất trong phòng thí nghiệm khi nói đến chiến việc dùng hợp chất này để chiến đấu với MRSA.

Các nhà nghiên cứu hiện đã có bằng sáng chế các hợp chất, nhưng vẫn đang trong quá trình tìm hiểu chính xác cơ chế hoạt động của chúng. Các xét nghiệm cho đến nay chỉ ra rằng các hợp chất này có một cấu trúc độc đáo, cho phép nó thâm nhập vào "màng sinh học" mà MRSA tạo ra để bảo vệ bản thân từ các phương pháp điều trị.
"Khi chúng ta dùng thuốc kháng sinh, các chất này đi theo vi khuẩn trong nước" McClintock nói - đó là lý do tại sao kháng sinh thường rất vô dụng trong việc chống lại MRSA.
"Darwinolide khác với các chất trước đây, chỉ có một phần nào tương tự các ứng cử viên thuốc từ bọt biển bởi vì nó có cấu trúc vòng trung tâm được sắp xếp theo một cách khác thường", Charles Amsler- một trong các nhà nghiên cứu cho biết.
Nếu các nhà nghiên cứu có thể cho thấy rằng họ có thể sử dụng darwinolide chống MRSA trong một thử nghiệm lâm sàng, thì nó có thể cứu sống hàng chục nghìn người mỗi năm, vì vậy rất nhiều người đang khá quan tâm để xem những gì sẽ xảy ra tiếp theo.
Nghiên cứu này đã được công bố trên Organic Letters.

Bình luận